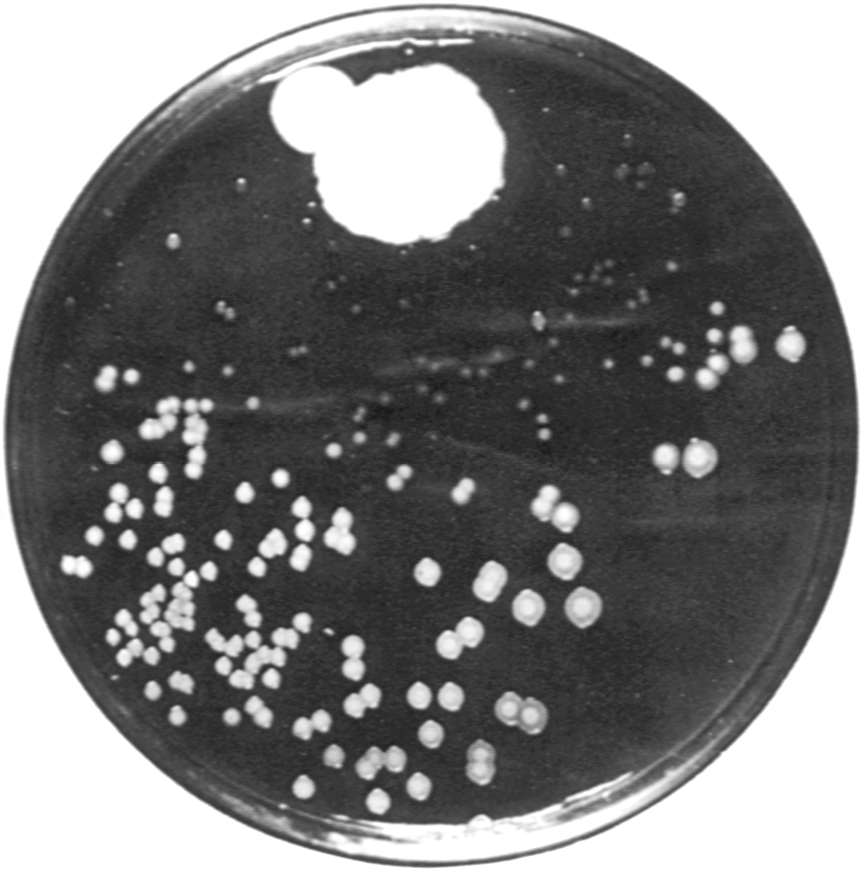

就在20世纪30年代之前,青霉素还没有问世,人类频频受到细菌的“侵袭”而又束手无策。妇女死于分娩,婴儿出生不久就夭折,儿童患了猩红热……即便是手指不小心扎了根刺或者皮肤划开一个微小的伤口,也可能因此而致命。类似这样的人间悲剧,随着青霉素的发现而逐渐消失了。
弗莱明发现青霉素,一半靠的是机遇,而另一半则靠他聪明的头脑和严谨的科学作风。“一战”期间,弗莱明曾在皇家军队医务队服役,不仅亲眼目睹了战争的残酷,而且也感受到了人类需要优质抗生素的迫切性。当时许多士兵由于伤口感染,医生们无法消毒,只好向伤口注入各种化学抗菌物质,但似乎效果不大。弗莱明在他的实验室里摆满了各种实验用的细菌培养皿,每天细心观察。有一次,他偶尔得了感冒,就取下一滴鼻涕放进培养皿里,几周以后,他发现培养基上长满了金黄色的菌落,在鼻涕的周围,也有菌落生长,但看上去是透明的,就像被溶解了似的。于是,一个问号在弗莱明脑海里产生了:这是否意味着鼻涕里含有某种杀菌的物质呢?
接下来的一周,弗莱明记录了更多的发现:人的皮肤、器官组织、头发、指甲甚至有些花木、蔬菜里都含有这种溶菌物质,它几乎无处不在。事实上,它是人体内的一种天然抗菌物,无非当时人们没有意识到。弗莱明把他的新发现命名为“溶菌酶”。
科学的发现,往往都有相似的一面,但只有有心人才会把握机遇,获取成功。1928年,奇迹再次在弗莱明的实验室发生一:次,他在清理培养皿时,意外地发现,他的葡萄球菌培养物已经被霉菌感染,而在霉菌生长的地方,葡萄球菌却在迅速分解。他小心地将霉菌分离出来,发现是其中的活跃物质抑制了葡萄球菌的生长。由于这霉菌来自于青霉菌类,他给它取名为青霉素。

弗莱明1921年在伦敦发现青霉菌的抗菌作用
弗莱明以科学家的严谨语言向世人公布了他的发现。此后,他继续不停地做实验,他发现,青霉素的“个性太活跃”,不容易稳定,无法将它提纯。直到1940年牛津大学的医学研究者恩斯特·钱恩和霍华德·弗洛里引进了另一种物质,才将青霉素加以稳定下来并提纯,从而投入大量生产。有意思的是,这一引进的物质就是弗莱明先前发现的“溶菌酶”。
一年后,青霉素首次在医学上应用。“二战”期间,青霉素成为战场上神奇的抗生素,大显神威,挽救了数以万计的生命,被称为“有魔力的子弹”。弗莱明因而被赞颂为英雄,1945年,他和钱恩以及弗洛里一起获得了诺贝尔生理学医学奖。
弗莱明第一次看到的生长有青霉素的培养皿
青霉素不仅治愈了那些受细菌感染而挣扎于死亡线上的人,它还赋予了医生从一开始就防止人体被细菌感染的“免疫”能力。大量的临床试验证明,青霉素是一种安全的药物,但也有一些人对它有过敏反应,少数过敏者会发生十分严重的反应,甚至死亡。至今,医生给病人打青霉素针时,也往往需要先做过敏试验。与弗莱明时代相比,我们今天已能够生产出各类不同的青霉素,有口服药,有注射剂。它们能够杀灭更多种的细菌。
一种少见的菌落出现在细菌培养皿上的机会是微乎其微的,而要被发现就更难了。只有训练有素、有远见且细心谨慎的科学家才可能通过细致的观察,不让任何微小的迹象逃过他的眼睛,奇迹往往总是这样发生的。青霉素的发现恰好说明了这一点。